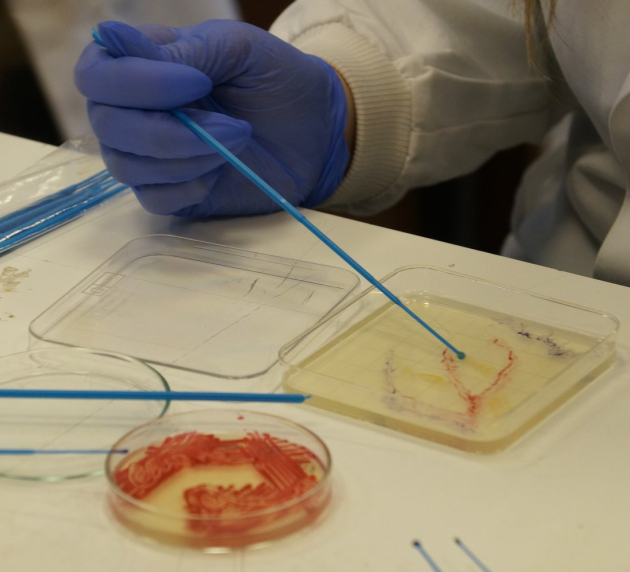
banner1
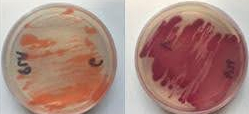
banner2

Join us at ASCUS Lab for a hands-on Bio-Art taster session, where science and creativity collide! 🌿🦠
In this unique session, you’ll paint with living bacteria, creating stunning artworks on agar plates using naturally pigmented microbes. Along the way, you'll learn the basics about microbiology, bacterial pigmentation, and how science can be a medium for artistic expression.
What to Expect:
- Learn basic microbiology lab techniques
- Create your own bio-art masterpiece on textiles
- Document your work & watch your art grow over time
- Explore the intersection of science and creativity
N.B. Bacteria takes time to grow so come back in 2 weeks to collect it
📍 Location: ASCUS Lab, Summerhall, Edinburgh
📅 Date & Time: Thursday 3rd April 2025, (Session One: 6pm-6:45pm) (Session Two: 7pm - 7:45pm)
No experience needed!
Book your spot now!
📸 Follow us on Instagram and Facebook @ascusartandscience

Share